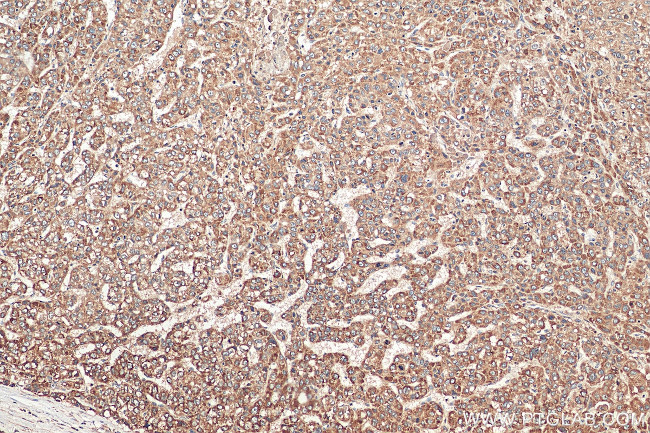
VTI1B Antibody in Immunohistochemistry (Paraffin) (IHC (P))
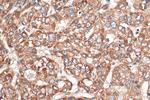
VTI1B Antibody in Immunohistochemistry (Paraffin) (IHC (P))

Search
Proteintech
VTI1B Polyclonal Antibody
{{$productOrderCtrl.translations['antibody.pdp.commerceCard.promotion.promotions']}}
{{$productOrderCtrl.translations['antibody.pdp.commerceCard.promotion.viewpromo']}}
{{$productOrderCtrl.translations['antibody.pdp.commerceCard.promotion.promocode']}}: {{promo.promoCode}} {{promo.promoTitle}} {{promo.promoDescription}}. {{$productOrderCtrl.translations['antibody.pdp.commerceCard.promotion.learnmore']}}
产品信息
14495-1-AP
种属反应
已发表种属
宿主/亚型
分类
类型
抗原
偶联物
形式
浓度
规格
纯化类型
保存液
内含物
保存条件
运输条件
产品详细信息
Immunogen sequence: KLHEIFRGL HEDLQGVPER LLGTAGTEEK KKLIRDFDEK QQEANETLAE MEEELRYAPL SFRNPMMSKL RNYRKDLAKL HREVRSTPLT ATPGGRGDMK YGIYAVENEH MNRLQSQRAM LLQGTESLNR ATQSIERSHR IATETDQIGS EIIEELGEQR DQLERTKSRL VNTSENLSKS RKILRSMSRK VTTNKLLLSI IILLELAILG GLVYYKFFRS H (13-232 aa encoded by BC003142)
靶标信息
V-SNARE that mediates vesicle transport pathways through interactions with t-SNAREs on the target membrane. These interactions are proposed to mediate aspects of the specificity of vesicle trafficking and to promote fusion of the lipid bilayers. May be concerned with increased secretion of cytokines associated with cellular senescence. Fischer von Mollard G., J. Biol. Chem. 273:2624-2630(1998). Li H.-C., Biochem. Biophys. Res. Commun. 247:70-74(1998).
仅用于科研。不用于诊断过程。未经明确授权不得转售。
生物信息学
蛋白别名: A novel SNARE; HGNC:17793; Soluble N-ethylmaleimide-sensitive factor-attachment protein receptor; unnamed protein product; vesicle transport through interaction with t-SNAREs 1B; vesicle transport through interaction with t-SNAREs 1B homolog; Vesicle transport through interaction with t-SNAREs homolog 1B; Vesicle transport v-SNARE protein Vti1-like 1; vesicle-associated soluble NSF attachment protein receptor; Vti1; Vti1-rp1; VTI1B
基因别名: AU015348; GES30; MVti1b; SNARE; v-SNARE; VTI1; VTI1-LIKE; Vti1-rp1; VTI1B; VTI1L; VTI1L1; VTI2
UniProt ID: (Human) Q9UEU0, (Rat) P58200
Entrez Gene ID: (Human) 10490, (Rat) 100359512, (Mouse) 53612